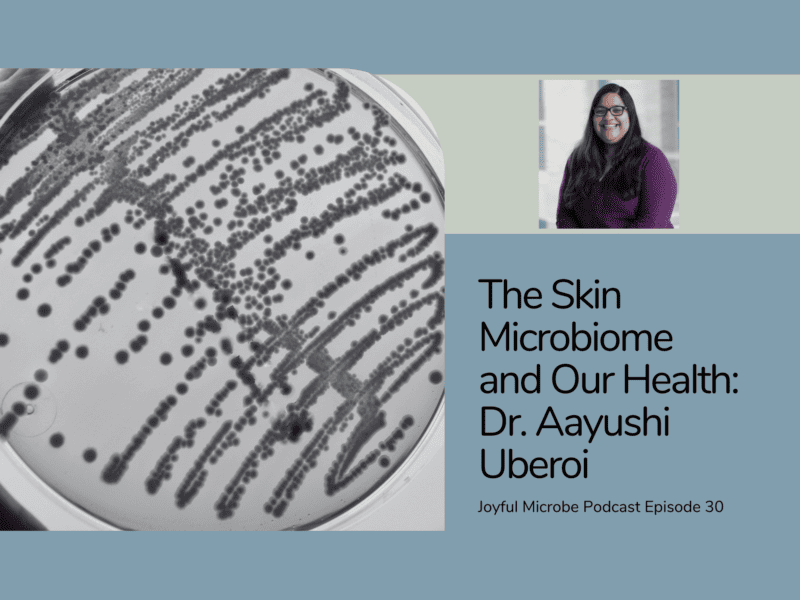

Aayushi Uberoi, Ph.D.
Principal investigator
Aayushi has studied interactions between microbes and skin since her Ph.D. research on cutaneous papillomaviruses in Dr. Paul Lambert’s lab at the University of Wisconsin-Madison. While traditional studies of infectious skin diseases have typically focused on singular pathogens within the host, skin is colonized by a diverse array of microbes, which likely exert significant influence on epithelial characteristics. Motivated by this question, Aayushi's postdoctoral research at the University of Pennsylvania in Dr. Elizabeth Grice’s lab explored the role of the commensal microbiome in regulating the function of the cutaneous barrier. In the lab, Aayushi wears several hats such as conducting research, developing protocols and assays, writing, and making sure the lab has fun equipment.
Favorite microbes
Papillomaviruses
Proteus mirabilis
Micrococcus luteus
Aayushi featured on the Joyful Microbe podcast
Aayushi featured by Thermo Fisher Scientific on Celebrating 40 Scientists in 40 Years
Invited lecture by Labroots on commensal microbiome and role in skin barrier function